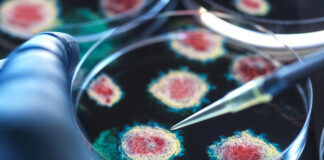
Учёные Сингапура: респираторно-синцитиальный вирус может быть схож с COVID-19

Учёные Сингапура: респираторно-синцитиальный вирус может быть схож с COVID-19
Респираторно-синцитиальный вирус, часто принимаемый за простуду, может быть сопоставим по тяжести и долгосрочному негативному влиянию на здоровье с гриппом и коронавирусной инфекцией COVID-19, выяснили...
Эпидемиолог Фаворов рассказал о влиянии антиковидных вакцин на онкологию
Директор компании DiaPrep Systems в Атланте, инфекционист и эпидемиолог Михаил Фаворов в интервью RT рассказал, что появились данные, что антиковидные вакцины оказывают положительное неспецифическое...
Врач Токарев рассказал, как отличить грипп от COVID-19
Главный внештатный специалист Министерства здравоохранения России по медицинской профилактике УрФО доктор медицинских наук Сергей Токарев рассказал, как отличить грипп от COVID-19.«Точно определить вирус может...
Эпидемиолог Фаворов высказался об экспериментах с коронавирусом в Ухане
Директор компании DiaPrep Systems в Атланте, инфекционист и эпидемиолог Михаил Фаворов заявил в интервью RT, что причиной пандемии коронавируса в мире стал низкий уровень...
Советник Байдена назвал «пощёчиной Бога» его болезнь в разгар предвыборной гонки
Советник экс-президента США Джо Байдена назвал «пощёчиной Бога» его заболевание ковидом в разгар предвыборной гонки.Об этом говорится в книге «Возмездие: Дональд Трамп и кампания,...
Роспотребнадзор следит за сообщениями о новом коронавирусе в Бразилии
Роспотребнадзор следит за сообщениями о новом коронавирусе, обнаруженном у летучих мышей в Бразилии.«По имеющейся информации, бразильские учёные выявили у небольшого вида насекомоядных летучих мышей...
Врач Маслиев: структура нового коронавируса отличается от COVID-19
Кандидат медицинских наук, член комиссии Госсовета «Продолжительная и активная жизнь», заведующий кафедрой превентивной медицины РУДН, основатель благотворительного фонда «Герои» Кирилл Маслиев рассказал, что структура...
Вирусолог Малинникова: COVID-19 сохраняет активность
Заведующая кафедрой вирусологии РМАНПО Минздрава России Елена Малинникова рассказала, что COVID-19 сохраняет активность в общей структуре заболеваемости.В пресс-центре МИЦ «Известия» Малинникова заявила, что в...
Врач Продеус: коронавирус перешёл в разряд банальных ОРВИ
Главный детский аллерголог-иммунолог Минздрава Московской области, заведующий кафедрой клинической иммунологии и аллергологии Высшей медицинской школы, д. м. н., профессор Андрей Продеус рассказал, что коронавирус...
Физиолог Серёжникова: костная ткань бедра может разрушаться после коронавируса
Ведущий научный сотрудник лаборатории цифрового микроскопического анализа Института регенеративной медицины Сеченовского университета, физиолог Наталья Серёжникова рассказала, что костная ткань бедра может разрушаться после перенесённого...